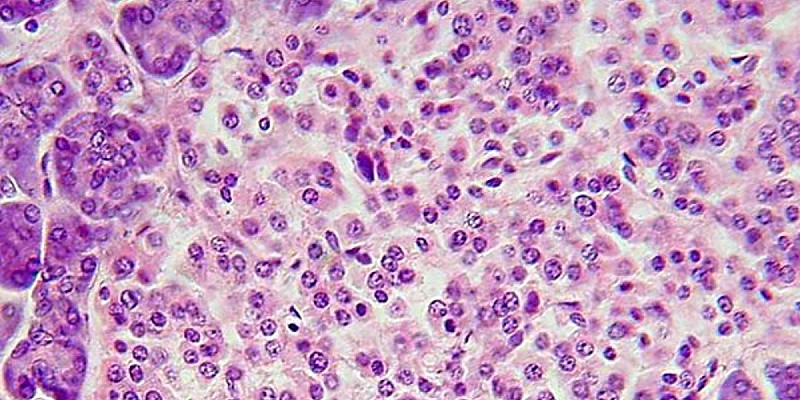
Langerhanssche_Insel

Trapianto isole pancreatiche, da studio italiano indicazioni per migliorare efficienza
Questo studio evidenzia il potenziale del trapianto di isole nel migliorare la qualità della vita dei pazienti con diabete a lungo termine, fornendo al contempo preziose indicazioni per ottimizzare le future terapie cellulari
Un nuovo studio dell'Irccs San Raffaele di Milano delinea le indicazioni fondamentali per migliorare l'efficacia e la sicurezza del trapianto di isole pancreatiche e indirizzare le future terapie per il trattamento del diabete di tipo 1. Il lavoro è stato pubblicato su 'The Lancet Diabetes & Endocrinology' e analizza i pazienti con diabete di tipo 1 trattati al San Raffaele dal 2001 al 2023. Coordinato dal professor Lorenzo Piemonti, primario dell'Unità di Medicina Rigenerativa e dei Trapianti, direttore del Diabetes Research Institute dell'Irccs San Raffaele e docente di Endocrinologia di UniSR Università Vita-Salute San Raffaele, lo studio rappresenta una delle analisi retrospettive a singolo centro più ampie al mondo, con un follow-up di vent'anni, e fornisce importanti indicazioni per le future terapie di sostituzione delle cellule beta nei pazienti con diabete di tipo 1.
L'analisi "ha coinvolto 79 pazienti di età compresa tra i 18 e i 67 anni, rivelando che nei soggetti con diabete di tipo 1 trattati con una dose di isole pancreatiche di almeno 10.000 Ieq/kg e il protocollo immunosoppressivo αCD25/FK506/Rapa, si è ottenuto un significativo miglioramento nella sopravvivenza del trapianto e una maggiore indipendenza dall'insulina. In questo gruppo, la sopravvivenza mediana delle isole è stata di 9,7 anni, con il 72,7% dei pazienti che ha mantenuto l'indipendenza dall'insulina per un periodo tra i 6 e i 7 anni".
I dati complessivi "mostrano una sopravvivenza del trapianto dell'86% a un anno, del 65% a cinque anni e del 40% a vent'anni, a conferma dell'efficacia a lungo termine del trattamento. Tuttavia, lo studio ha evidenziato alcuni effetti collaterali associati alla terapia immunosoppressiva, come infezioni e riduzione della funzionalità renale, che richiedono un attento monitoraggio e interventi mirati per garantire la sicurezza a lungo termine dei pazienti", riporta lo studio.
"Questo studio evidenzia il potenziale del trapianto di isole nel migliorare la qualità della vita dei pazienti con diabete a lungo termine, fornendo al contempo preziose indicazioni per ottimizzare le future terapie cellulari, in particolare quelle basate sul differenziamento delle isole pancreatiche a partire da cellule staminali", ha spiegato il professor Lorenzo Piemonti.
"I risultati ottenuti non solo aiutano a comprendere meglio gli effetti dell'immunosoppressione, ma anche a determinare le dosi ottimali di isole per garantire trapianti sicuri ed efficaci. Questi dati sottolineano l'importanza di proseguire la ricerca per migliorare e perfezionare le terapie cellulari destinate ai pazienti con diabete di tipo 1, per garantire trattamenti sempre più efficaci e sostenibili nel lungo periodo", ha concluso Piemonti.
nostri canali social seguendoci su:















 Eurosets presenta Landing Advance, un sistema completo e intuitivo che apre nuove frontiere nel campo del monitoraggio multiparametrico in cardiochirurgia...
Eurosets presenta Landing Advance, un sistema completo e intuitivo che apre nuove frontiere nel campo del monitoraggio multiparametrico in cardiochirurgia...






